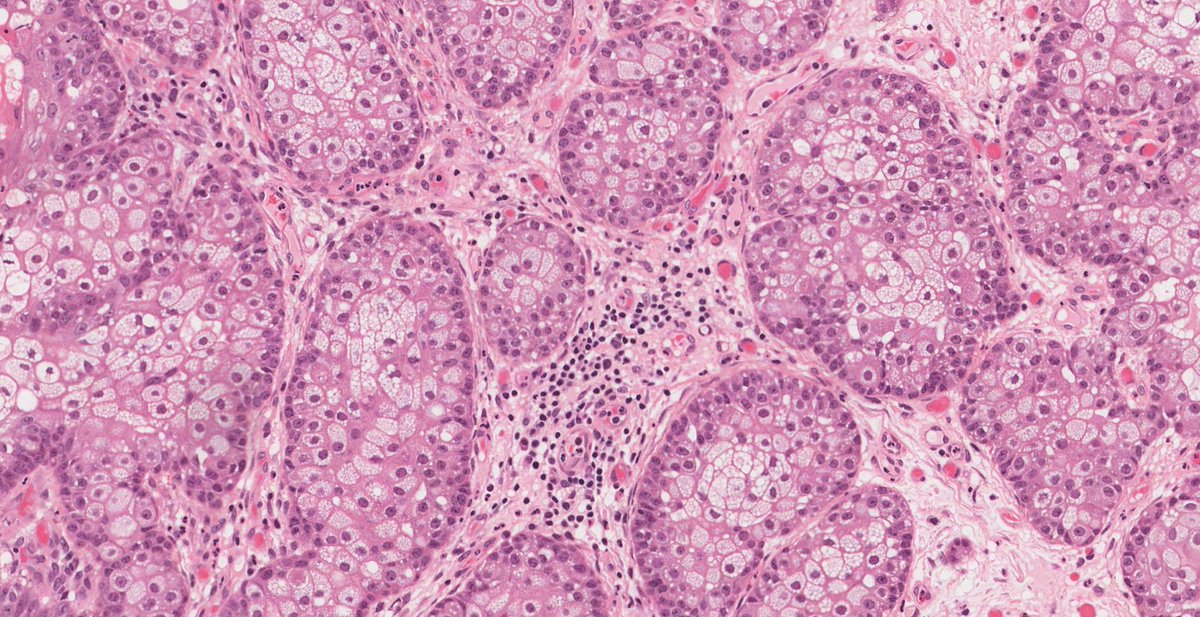

المناعة تعرفها على أنها جنين و جزء من جسم الإنسان ويجب أن يمده الجسم بالأوعية الدموية بغض النظر عن مكانه
وهنا يصيـر الجسم يغذيه الى غايةأن السرطان يكبر ويختفي الغشاء وهنــا يتحول من سرطان حميد إلى سرطان خبيث ويبدأ ينتشر بسرعة أكبر ويصل لدرجة خطيرة
وهنا يصيـر الجسم يغذيه الى غايةأن السرطان يكبر ويختفي الغشاء وهنــا يتحول من سرطان حميد إلى سرطان خبيث ويبدأ ينتشر بسرعة أكبر ويصل لدرجة خطيرة
وتبدأ الاعراض تظهر على الشخص من آلالم وضعف لا نكتشفها إلا في مرحلة متأخرة..
السبب الأساسي :- أنه يحيط نفسه بغشاء يسمى الغشاء الجنيني
عافانا الله وإياكم..
السبب الأساسي :- أنه يحيط نفسه بغشاء يسمى الغشاء الجنيني
عافانا الله وإياكم..
الكركم
بحسب الدراسات فان الكركم يستطيع ايقاف نمو الخلايا السرطانية حتى الموت عن طريق العمل ضد الأوعية الدموية المُغذية للخلايا السرطانية.
الأوريجانو
يُساعد على الحدّ مِن انتشار الخلايا السرطانية مِن خلال عملهِ كمُطهر، ويوجد الكارفاكرول أيضاً في العديد مِن الأعشاب الأُخرى
مِنها المردقوش، والنعناع، والزعتر، والريحان، والبقدونس
بذور الكتان
بحسب الدراسات فان الكركم يستطيع ايقاف نمو الخلايا السرطانية حتى الموت عن طريق العمل ضد الأوعية الدموية المُغذية للخلايا السرطانية.
الأوريجانو
يُساعد على الحدّ مِن انتشار الخلايا السرطانية مِن خلال عملهِ كمُطهر، ويوجد الكارفاكرول أيضاً في العديد مِن الأعشاب الأُخرى
مِنها المردقوش، والنعناع، والزعتر، والريحان، والبقدونس
بذور الكتان
زيت الزيتون يحارب السرطان
عُرف زيت الزيتون بقدراته المتعددة منذ اكتشافه، فهو رائع إذا ما تم تناوله عن طريق الفم، ورائع إذا ما تم استعماله للشعر، ومفيد للبشرة أيضًا، ومؤخرًا تمددت قدراته لتشمل محاربة السرطان، وذلك وفقًا لفريق من الباحثين من جامعة روتجرز وكلية هانتر، حيث تبين بأن تناول زيت الزيتون يقضي على الخلايا السرطانية خلال أقل من ساعة.
عُرف زيت الزيتون بقدراته المتعددة منذ اكتشافه، فهو رائع إذا ما تم تناوله عن طريق الفم، ورائع إذا ما تم استعماله للشعر، ومفيد للبشرة أيضًا، ومؤخرًا تمددت قدراته لتشمل محاربة السرطان، وذلك وفقًا لفريق من الباحثين من جامعة روتجرز وكلية هانتر، حيث تبين بأن تناول زيت الزيتون يقضي على الخلايا السرطانية خلال أقل من ساعة.
أعراض تحول الخلايا إلى خلايا سرطانية
بعد أن تتحول الخلايا إلى خلايا سرطانية تظهر مجموعة من الأعراض التي تختلف باختلاف الجزء المُصاب بالجسم
ضعف عام والإرهاق بالجسم.
اضطرابات بالوزن، حيث يكون هناك زيادة أو نقصان بالوزن بصورة غير مُبررة.
ظهور بعض التغيرات بالجلد، مثل: اصفرار أو احمرار الجلد، وظهور تهيج وتقرحات جلدية دائمة.
تغير في مواقع الشامات بالجسم.
صعوبة في التنفس، والسعال الدائم.
وجود بحة في الصوت، ومواجهة صعوبة في بلع الطعام.
وجود بعض الكدمات بالجسم، والنزيف المستمر غير المُبرر.
مواجهة مشكلات في الهضم، مثل: عُسر الهضم، وضيق بعد تناول الطعام.
مواجهة بعض التغيرات في الأمعاء والمثانة عند البعض.
ألم متواصل في العضلات والمفاصل بصورة غير اعتيادية.
التعرق الليلي الزائد، وقد يُصاحبه الإصابة بالحمى
بعد أن تتحول الخلايا إلى خلايا سرطانية تظهر مجموعة من الأعراض التي تختلف باختلاف الجزء المُصاب بالجسم
ضعف عام والإرهاق بالجسم.
اضطرابات بالوزن، حيث يكون هناك زيادة أو نقصان بالوزن بصورة غير مُبررة.
ظهور بعض التغيرات بالجلد، مثل: اصفرار أو احمرار الجلد، وظهور تهيج وتقرحات جلدية دائمة.
تغير في مواقع الشامات بالجسم.
صعوبة في التنفس، والسعال الدائم.
وجود بحة في الصوت، ومواجهة صعوبة في بلع الطعام.
وجود بعض الكدمات بالجسم، والنزيف المستمر غير المُبرر.
مواجهة مشكلات في الهضم، مثل: عُسر الهضم، وضيق بعد تناول الطعام.
مواجهة بعض التغيرات في الأمعاء والمثانة عند البعض.
ألم متواصل في العضلات والمفاصل بصورة غير اعتيادية.
التعرق الليلي الزائد، وقد يُصاحبه الإصابة بالحمى
جاري تحميل الاقتراحات...